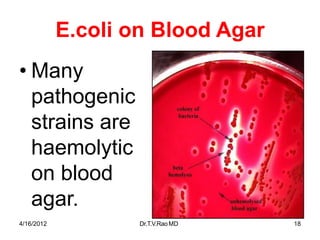
E.coli on Blood Agar
• Many
pathogenic
strains are
haemolytic
on blood
agar.
4/16/2012 Dr.T.V.RaoMD 18
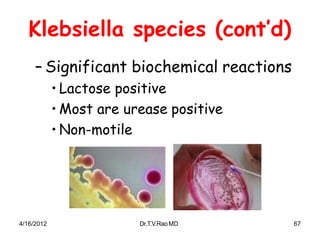
Klebsiella species (cont’d)
– Significant biochemical reactions
• Lactose positive
• Most are urease positive
• Non-motile
4/16/2012 Dr.T.V.RaoMD 67
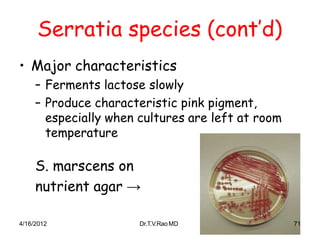
Serratia species (cont’d)
• Major characteristics
– Ferments lactose slowly
– Produce characteristic pink pigment,
especially when cultures are left at room
temperature
S. marscens on
nutrient agar →
4/16/2012 Dr.T.V.RaoMD 71

The document discusses the Enterobacteriaceae family of bacteria. It notes that they are commonly found in the large intestine of humans and are gram-negative rods that ferment glucose with acid production and reduce nitrates. The document provides classifications of Enterobacteriaceae and describes some characteristics and pathogenic members like Escherichia coli. It summarizes methods for identifying lactose fermenters versus non-fermenters and discusses virulence factors and toxins produced by pathogenic E. coli strains.